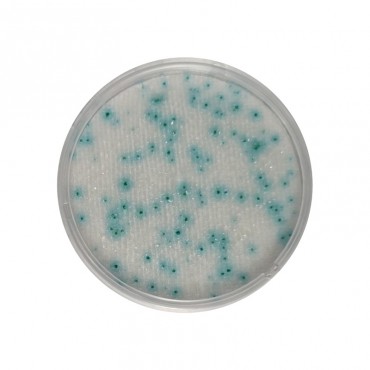
CompactDry™ YM (Yeasts & Molds) Compact Dry Compact Dry
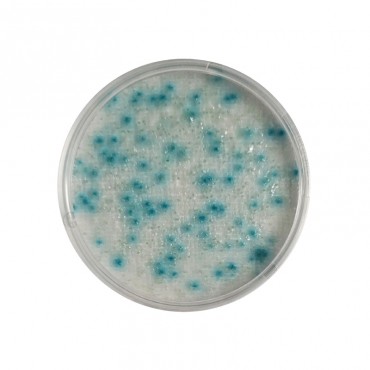
CompactDry™ YMR (Yeasts & Molds Rapid) Compact Dry Compact Dry

CompactDry™ E. coli & coliforms (EC)
CAD$387.35
Compact Dry
Compact Dry is a ready to use culture media cassette for the enumeration of various bacteria types . Compact Dry uses chromogenic determination of bacteria to simplify the differential enumerations
There are 10 products.
Sort by: